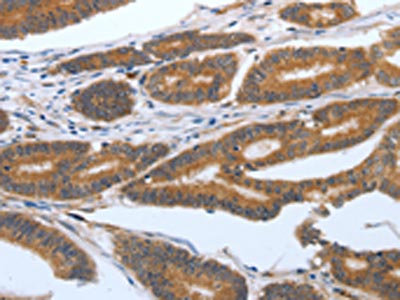

PODXL Antibody
-
中文名稱:PODXL兔多克隆抗體
-
貨號(hào):CSB-PA568085
-
規(guī)格:¥1100
-
圖片:
-
The image on the left is immunohistochemistry of paraffin-embedded Human colon cancer tissue using CSB-PA568085(PODXL Antibody) at dilution 1/25, on the right is treated with synthetic peptide. (Original magnification: ×200)
-
The image on the left is immunohistochemistry of paraffin-embedded Human ovarian cancer tissue using CSB-PA568085(PODXL Antibody) at dilution 1/25, on the right is treated with synthetic peptide. (Original magnification: ×200)
-
-
其他:
產(chǎn)品詳情
-
Uniprot No.:
-
基因名:
-
別名:GCTM-2 antigen antibody; Gp2 antibody; Gp200 antibody; MGC138240 antibody; PC antibody; PCLP antibody; PCLP-1 antibody; PCLP1 antibody; Pcx antibody; Podocalyxin antibody; Podocalyxin like antibody; Podocalyxin like protein antibody; Podocalyxin-like protein 1 antibody; Podxl antibody; PODXL_HUMAN antibody
-
宿主:Rabbit
-
反應(yīng)種屬:Human
-
免疫原:Synthetic peptide of Human PODXL
-
免疫原種屬:Homo sapiens (Human)
-
標(biāo)記方式:Non-conjugated
-
抗體亞型:IgG
-
純化方式:Antigen affinity purification
-
濃度:It differs from different batches. Please contact us to confirm it.
-
保存緩沖液:-20°C, pH7.4 PBS, 0.05% NaN3, 40% Glycerol
-
產(chǎn)品提供形式:Liquid
-
應(yīng)用范圍:ELISA,IHC
-
推薦稀釋比:
Application Recommended Dilution ELISA 1:1000-1:5000 IHC 1:25-1:100 -
Protocols:
-
儲(chǔ)存條件:Upon receipt, store at -20°C or -80°C. Avoid repeated freeze.
-
貨期:Basically, we can dispatch the products out in 1-3 working days after receiving your orders. Delivery time maybe differs from different purchasing way or location, please kindly consult your local distributors for specific delivery time.
-
用途:For Research Use Only. Not for use in diagnostic or therapeutic procedures.
相關(guān)產(chǎn)品
靶點(diǎn)詳情
-
功能:Involved in the regulation of both adhesion and cell morphology and cancer progression. Functions as an anti-adhesive molecule that maintains an open filtration pathway between neighboring foot processes in the podocyte by charge repulsion. Acts as a pro-adhesive molecule, enhancing the adherence of cells to immobilized ligands, increasing the rate of migration and cell-cell contacts in an integrin-dependent manner. Induces the formation of apical actin-dependent microvilli. Involved in the formation of a preapical plasma membrane subdomain to set up initial epithelial polarization and the apical lumen formation during renal tubulogenesis. Plays a role in cancer development and aggressiveness by inducing cell migration and invasion through its interaction with the actin-binding protein EZR. Affects EZR-dependent signaling events, leading to increased activities of the MAPK and PI3K pathways in cancer cells.
-
基因功能參考文獻(xiàn):
- s-Podxl is independently associated with carotid IMT and might be used as a novel biomarker for cardiovascular disease. PMID: 29321582
- Results show high podocalyxin expression in prostate cancer and can be used as a tumor marker for disease progression and patients stratification. PMID: 30396958
- Summary of the structural features of podocalyxin glycoforms from embryonic and induced pluripotent stem cells (review). PMID: 28980094
- This set of symptoms strikingly mimics previously reported mouse Podxl(-/-) embryos, emphasizing the essential function of PODXL in mammalian kidney development and highlighting this patient as a human PODXL-null model. PMID: 29244787
- These results indicate that PcMab-47 is useful in detecting podocalyxin of oral cancers for immunohistochemical analysis PMID: 28873000
- expression of PODXL associates with TAZ downstream gene expression. Suppression of PODXL induces phosphorylation of LATS1 and TAZ, and is accompanied with a decrease in TAZ protein expression. We speculate that changes in actin cytoskeleton may participate in PODXL-mediated TAZ signaling. PMID: 28946619
- Results show that PODXL performs as a tumor promoter in gastric tumor cells (GC). PODXL is a target gene of miR-509-3-5P; the ectopic expression of miR-509-3-5P in GC cell lines inhibits the colony, motility and invasion abilities via negatively targeting PODXL. PMID: 28432273
- Podocalyxin as a major pluripotent marker and novel keratan sulfate proteoglycan in human embryonic and induced pluripotent stem cells. PMID: 28078490
- A novel frameshift mutation in PODXL seems to be the likely cause of ARJP in this family. PMID: 26864383
- These findings suggest a potential functional link in colorectal cancer between PODXL, EGFR and BRAF. PMID: 27160084
- PODXL enhances motility and invasiveness through an increase in gelsolin-actin interactions in cell protrusions. PMID: 27461278
- Results identify an anti-metastatic miRNA, miR-5100, that decreases the metastatic ability of pancreatic cancer partially by suppressing expression of PODXL. PMID: 26892887
- Results indicate that urinary podocalyxin is not only an early marker but also a treatment target for diabetic nephropathy (DN). PMID: 26635084
- Obese subjects showed evidence of renal alteration through the detection of a higher number of urinary podocalyxin positive cells. PMID: 25905599
- Data show that both mucin16 (MUC16) and podocalyxin (PODXL)-E-selectin-mediated interactions are mechanically stronger than like L-selectin interactions at the single-molecule level. PMID: 26329844
- In gastric cancer, PODXL expression by the polyclonal antibody HPA2110 is an independent marker of poor prognosis. PMID: 26674770
- PCX promotes cisplatin chemoresistance in osteosarcoma cells through a PI3Kdependent mechanism. PMID: 26017117
- EZR, CLIC5 and PODXL are overexpressed in hepatocellular carcinoma and may have a role in cell migration and invasiveness PMID: 26135398
- PODXL up-regulates the expression level of Bmi1 in OTSCC cells. PMID: 25915207
- podocalyxin to be an independent factor for poor prognosis in PDAC. To our knowledge, this is the first such report of its prognostic value. PMID: 26053486
- miR-125b was found to be important in arteriosclerosis obliterans by suppressing the expression of PODXL and may serve as a potential therapeutic target for the treatment of arteriosclerosis obliterans. PMID: 25738314
- We show that podocalyxin plays a key role in the formation of primary tumors and distant tumor metastasis. PMID: 25887862
- PCLP1 expressed on breast tumor cells may function as an immunomodulatory molecule, which may represent a mechanism to evade the immune response. PMID: 26276714
- These findings show that overexpression of PODXL enhanced invadopodia formation and tumor metastasis by inducing Rac1/Cdc42/cortactin signaling network. PMID: 24970760
- overexpression of PODXL may be associated with human oral squamous cell carcinoma aggressiveness PMID: 24821609
- A variant form of PODXL remains the most likely candidate causing focal and segmental glomerulosclerosis in a family with autosomal dominant inheritance. PMID: 24048372
- Suggest that analysis of PODXL expression in the primary tumour is sufficient for its use as a prognostic and treatment predictive biomarker in colorectal cancer, also in patients with metastatic disease. PMID: 23819542
- Urinary Podocalyxin positive-element may be a noninvasive marker for the early stage of Diabetic nephropathy. PMID: 24075693
- TRA-1-81 is expressed only in the cytoplasm of uterine smooth muscle neoplasms. PMID: 24143384
- PODXL is expressed in glioblastoma multiforme stem-like cells and is involved in cell proliferation and oncosphere formation. PMID: 24146797
- Membranous PODXL expression is an independent risk factor for progressive disease and death in patients with urothelial bladder cancer PMID: 23652315
- The results obtained indicate that integrity of the PODXL ectodomain is essential for enhancing cell adhesion but not migration, while the integrity of the cytoplasmic domain is required for both adhesion and migration. PMID: 23396057
- PODXL protein expression was analyzed n tissue microarrays with colorectal cancer tumor samples. High PODXL protein expression was significantly associated with unfavourable clinicopathological characteristics in both cohorts. PMID: 22769594
- PODXL has the potential to be a useful biomarker for identifying good prognosis patients in characteristically poor prognosis breast cancer groups and may impact treatment of women with this disease. PMID: 23288345
- podocalyxin, a heavily glycosylated type 1 transmembrane protein, is a glycoprotein ligand of recombinant N-terminal domain of the lectin BC2L-C from Burkholderia cenocepacia on human induced pluripotent stem cells and embryonic stem cells. PMID: 23526252
- Levels of urinary PCX and the number of urinary podocytes are associated with histologic abnormalities in adults with IgA nephropathy. PMID: 22700887
- Sialofucosylated PODXL is a functional E-and L-selectin ligand expressed by metastatic pancreatic cancer cells. PMID: 22814396
- Most AML patients had a significant decrease in miR-199b-5p levels with elevated PODXL & DDR1 expressions. Both PODXL & DDR1 are targets of miR-199b-5p. PMID: 22374871
- podocalyxin's ability to facilitate the formation of non-adhesive membrane domains may contribute to the formation of free-floating high grade serous tumor nodules during the initial steps of transperitoneal metastasis. PMID: 22262060
- Podocalyxin-like 1 expression is an independent factor of poor prognosis in colorectal carcinoma. PMID: 21829192
- The urinary mRNA profiles of synaptopodin, podocalyxin, CD2-AP, alpha-actin4, and podocin were found to increase with the progression of diabetic nephropathy. PMID: 21655212
- This report identifies DNA methylation, miR-199a dysregulation and PODXL as critical factors in tumor malignancy. PMID: 21383689
- PINCH1 is transcriptional regulator in podocytes that interacts with WT1 and represses podocalyxin expression. PMID: 21390327
- intact PODXL is released to the extracellular space as a cargo of microvesicles and also as a soluble cleaved fragment of ectodomain PMID: 21616097
- Data show that podocalyxin overexpression in human embryonic kidney cells up-regulates Rac1 activity, which depends on a complex formed by podocalyxin, ERM-binding phosphoprotein 50, ezrin, and ARHGEF7, a Rac1 activator. PMID: 20395446
- In pluripotent stem cells and in human cancer disease, podocalyxin may function in part to regulate and maintain the cell surface expression of the glucose-3-transporter. PMID: 20599725
- podocalyxin has a role in defining the structure of the podocyte basal surface PMID: 15226400
- Overexpression of the anti-adhesin podocalyxin is associated with breast cancer progression PMID: 15289306
- PODXL variants are implicated in prostate neoplasm aggressiveness, with gene mapping to chromosome 7q32-q33. PMID: 16434482
- Transcriptional regulation of Podxl is supported primarily by Sp1 site(s) and that DNA-methylation of the CpG promoter islands contributes to control the tissue specific expression of podxl. PMID: 16684343
顯示更多
收起更多
-
亞細(xì)胞定位:Apical cell membrane. Cell projection, lamellipodium. Cell projection, filopodium. Cell projection, ruffle. Cell projection, microvillus. Membrane raft. Membrane; Single-pass type I membrane protein.
-
蛋白家族:Podocalyxin family
-
組織特異性:Glomerular epithelium cell (podocyte).
-
數(shù)據(jù)庫(kù)鏈接:
Most popular with customers
-
-
YWHAB Recombinant Monoclonal Antibody
Applications: ELISA, WB, IHC, IF, FC
Species Reactivity: Human, Mouse, Rat
-
Phospho-YAP1 (S127) Recombinant Monoclonal Antibody
Applications: ELISA, WB, IHC
Species Reactivity: Human
-
-
-
-
-